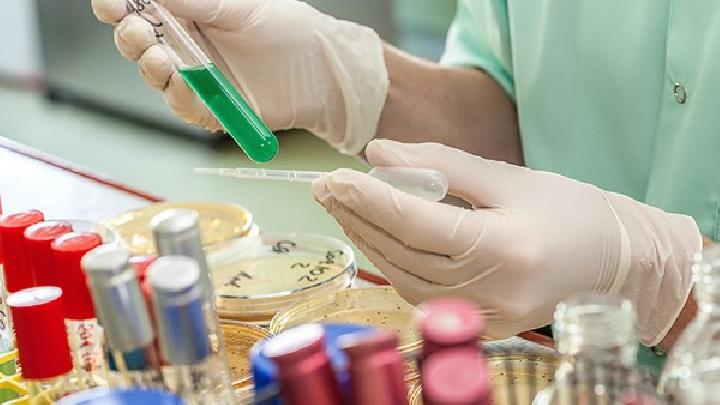
慢性粒细胞白血病的化学治疗

到目前为止,慢性粒细胞白血病患者只能依靠药物治疗。从一个角度来看,这种感觉疾病也是一种恶性肿瘤疾病。因此,我们将在临床上采用化学治疗,但患者治疗后会有很多预防措施,现在我们将总结本病的相关预防措施。
有效药物有BUS(马利兰),HU(羟基脲),CTX、CLB、6-MP(6-、MMC(丝裂霉素)。HU其次是首选药物BUS。
HU每天开始剂量3g,口服。白细胞数量在使用后两三天迅速下降,停药后迅速恢复。20×109/L将剂量降到一半左右;降到一半10×109/L时,将剂量再减少。维持剂量约每日0.5g~1.0g。为了调节药物剂量,需要经常检查血象。该药具有效果快、不良反应少、耐受性好、与烷化剂无交叉耐药性等优点。是目前首选的化疗药物和基础治疗药物。
BUS目前临床应用很少。2mg一天三次,直到白细胞降到14×109/L以下停药或间歇给药。一般规律是用药1~2周,症状明显好转,4~6周明显好转。当白细胞减少到10×109/L减少到1~2mg/d,持续2~3个月。停药后,如白细胞波动在(10~50)×109/L小剂量可考虑维持一年以上。白细胞减少到(5~10)×109/L血小板在100×109/L以下,或有慢粒急变倾向的,应停药。
马利兰的毒副作用主要是骨髓抑制,尤其是血小板减少。虽然个别患者用药量小,但全血细胞减少,恢复缓慢。长期服用此药物可引起肺纤维化和皮肤色素沉着。类似于慢性肾上腺皮质功能减退、精液缺乏或更年期的症状。
以上我们总结了慢性粒细胞白血病的化学治疗方法,但需要注意的是要掌握该病药物的副作用,随时给予患者积极的护理。此外,我们还需要照顾慢性粒细胞白血病患者的心理,增强他们战胜疾病的信心。
